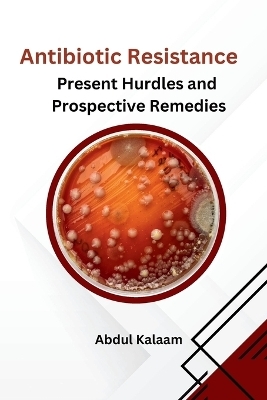
Recurrent Neural Nets for Focal Cortical Dysplasia Detection in Brain MRI.

The Story Doesn't End with Dementia
Buch | Softcover
2023
|
FriesenPress
ISBN: 9781039169333
CHF 35,15 (inkl. MwSt)
- Keine Verlagsinformationen verfü
gbar